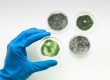

Professional mold remediation costs an average of $2,215 in the U.S. in 2021. Prices for this project will range from $1,121-$3,331, according to HomeAdvisor.
Average Mold Remediation Costs
All significant remediation projects need to be done by professionals. Nevertheless, smaller removal projects (usually under 10 sq ft) may be done as a weekend project. This could cost as little as $10 to $50, with larger projects costing as high as $6,000. Predictably, there are a multitude of factors that affect your budget for removal. The amount of growth mixed in with the degree of decomposition might require replacing some of the current materials.
Mold Remediation Cost Per Square Foot
A lot of mold remediation professionals are going to charge an average of $17.50 for each sq ft for removal. Costs are going to range between $10 to $25. For instance, if you are required to remove a 100 sq ft room, the project is going to cost you between $1,000 to $2,500. Where the growth is, is the biggest factor when it comes to costs.
DIY Removal Or Hire Professionals?
Of course, homeowners are going to be able to carry out smaller remediation projects. Actually, if the impacted area is 10 sq ft or less, the EPA reports property owners can take on the projects themselves. Following the area being inspected by a professional, inquire if you would be able to carry out the cleanup task on your own.
DIY Mold Removal Tips
The removal of larger mold invasions is going to require additional work and safety precautions comprising of:
Removal of Molded Carpet
Cut the moldy or stained carpet and padding into 6 x 8 ft sections using a utility knife. With use of a pump sprayer, spray the surfaces with water to hinder the spreading of spores and then roll up the sections. Double wrap the rolled-up sections in 6-mil plastic and then duct tape it. Make sure you’re wearing protective clothing and run an exhaust fan out your window.
Seal Off the Damaged Area
Seal off the room from the rest of your home. Cover the doorway with overlapping plastic, then tape it to your floor and wall. Cover the air ducts with plastic and tape.
Open the Moldy Walls Up
Extract the trim and baseboards off the affected areas using a pry bar and piece of wood. Examine the area with a screwdriver to locate and open the moisture damage and concealed mold in your insulation and the walls framing.
Moisten and Bag Moldy Materials
Turn the electric off to the room and cut the wall open with a saw or utility knife. Spray your insulation and drywall using a pump sprayer to stop the mold spores from circulating. Double bag the materials using heavy-duty bags and seal them shut.
You are able to scour surface mold off of your decks, siding, and bathroom in minutes with a 1 to bleach/water combination. Usually, the mold is going to grow and spread in areas that aren’t noticed until you see stained surfaces and feel spongy drywall or notice a moldy smell.
When you must remove mold that covers more than just a couple of feet, it is suggested that you take preventive measures. You are going to want to avoid contaminating the home but to also safeguard yourself from breathing in too many volatile organic compounds and spores.
- Wear older shoes and clothes that you are able either throw away or clean following clean-up.
- Wear p-100 or n-95 respirators in addition to gloves and eye protection.
- Place a fan in a window for ventilating the room when working. Throw it away when you are finished since the spores are difficult to clean. Tape plastic around the opening of the window so the spores aren’t able to enter again.
- Wrap and tape your carpet in plastic and double bag moldy refuse in garbage bags for removal.
- To retain the spores from moving airborne, moisten the areas with a pump sprayer.
- Turn off your AC and furnace and open-up doors and ducts.
- Retain the wet/dry vac outside when you’re vacuuming.
Mold and Drywall
You should open up the wall to get to the form growing inside. Because you’ll need to repair the wall at anyway, don’t dither to curb past the obvious harm to find all the form and allow the wall dry out. To stop from cutting wires, make an opening close to the area and locate the wires. Turn off the electricity to outlets prior to you cutting the wall.
In the case that the damage has been neglected, you might discover that there is rot. Where viable, remove and replace light studs, and wall coverings. Where there are problems, treat the wood with a supplement to clean it and allow it to dry.
Mold Remediation Services
The initial key to identifying mold is being mindful of what precisely the growth looks like. Mold basically grows everywhere. The growth comes from miniscule spores that float through the air. Mold is going to grow in areas that stay between 40 to 100 degrees. Typically speaking, mold is most common in moist parts of homes or commercial buildings. Mildew is the simplest kind of mold to identify. Its black coloring makes it obvious. This type only gets bigger as time goes on, expanding into colonies. Examine damp areas, including your shower corners and siding for indication of mildew growth. Don’t be yielding when checking for mold. Its generally simple to identify but a lot of homeowners could pass it by, thinking it is simply dirty.
Hiring a Professional
Don’t think you can trust your eyes to identify mold growth on your own? Calm down, there are reliable professionals that can carry out such a task! Professional mold inspections comprise of a comprehensive examination of your property. Every wall covering, drywall and nooks and crannies inside and outside the property are going to be inspected. After mold growth is identified, the initial duty for the inspectors is to repair the issue that caused the mold to begin with. Meaning any leaks or overflow of water is going to be worked on prior to the remediation process beginning. Professional remediation needs to include appropriate removal, followed by a clean-up applying biocide.
Free Mold Remediation Cost Estimates In Phoenix, Arizona
If you are wondering how much your water damage repair service will cost, Restoration Services LTD provides free water damage cost estimates throughout the entire Phoenix valley of Arizona. Give us a call today or use our contact form to get in touch with us.
CONTACT US TODAY! CALL 602-309-1116 FOR VALLEYWIDE SERVICES, AND CALL 602-867-7771 FOR STATEWIDE SERVICES!